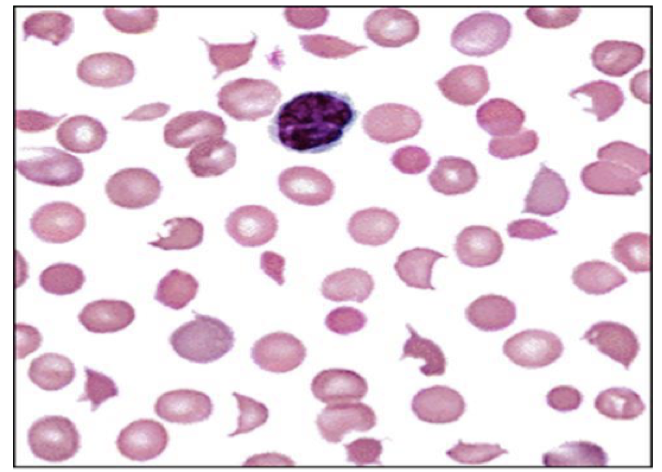

If you suspect that your patient has a deep vein thrombosis in their lower leg, what would be your next stop in her management?
Ultrasound of the lower extremity to evaluate for thrombosis.
Your patient with a DVT is given enoxiparin for anticoagulation. She is transitioned for apixaban and treated for 3 mo. Three years after her initial presentation she begins to experience SOB, difficulty climbing stairs, and chest pain. In the ED, her CT shows a PE. What hemetologic deficiencies could contribute to this presentation?
What is Factor V Leiden?
A polymirphism in factor V that causes resistance to degradation by activated protein C (normally factor C degrades factor 5 but in this disease it cannot.)
People with low levels of what are at risk of warfarin related skin necrosis?
Protein C and S.
This is because warfarin decreases vitamin K and protein C and S are vitamin K dependent and thus their levels will DECREASE when you give warfarin. Decreased levels of C and S result in hypercoagulability (even though technically warfarin is anti-coagulating).
Antithrombin reacts with what two things to inhibit their activity?
Thrombin and activated factor X are inhibited by antithrombin.
If you have a patient who you suspect has a clot, would you want to know her Factor V Leiden status? What is the single biggest risk factor for clotting?
NO! Factor V leiden only predicts your initial risk of clotting, not the chance of reoccurence.
The single biggest risk factor for clotting is age. So a young person with a clot is a lot more concerning for reoccurence than an old person with a clot.
What are the risk factors for venous thrombosis?
Virchow’s Triad!:
What does diagnosis of DVT and PE require?
The combined use of pretest probability tools (Wells score) plus lab (D-dimer) and imaging (usually ultrasound but sometimes CT or MRI).
The Well’s score is used to predict the probability of clotting.
What anticoagulants work by inhibiting factor Xa (there are 6)? How is each given?

What anticoagulants work by inhibiting factor IIa (there are 5)? How is each given?

Describe the following as it pertains to warfarin:
Onset: slow
Food interactions: significant (leafy greens)
Drug interactions: many!
Is the drug reaction predictable?: No
Is there an antidote?: Yes
Describe the following as it pertains to DOACs?:
Onset: Rapid!
Food interactions: Minimal
Drug interactions: Few
Is the drug reaction predictable?: Yes
Is there an antidote?: Yes, but it’s expensive and less available.
What is the most common known inherited thrombophilia? What population is the gene relatively common in?
INHERITED RESISTANCE to activated PRotein C (APC) and Factor V Leiden.
Approximately 5-6% of caucasians are heterozygous for the factor V leiden mutation.
What is the cause of Factor V Leiden?
A point mutation in the factor V gene that results in an Argining > Glutamine translocation at amino acid 506 (FV-R506Q).
Position 506 is the initial site of cleavage of Factor Va by activated protein C. Therefore, factor Va is relatively resistance to inactivation.

If your patient is pregnant and has thrombocytopenia, what test would you want to do?
A peripheral blood smear! THIS IS THE HEME UNIT PEOPLE.
You order a peripheral blood smear on your pregnant with thrombocytopenia and it looks like the attached image. What is the mechanism accountable for the patient’s peripheral blood smear?
A mechanical shearing of RBCs with consumption of platelets.
What is the function of ADAMTS13? What does it mean if it’s low?
It chops up vWF.
If it’s low, platelets stick to the large vWF.
What is the pentad of clinical manifestations of thrombotic thrombocytopenic purpura (TTP) - microvascular inarction?
If your patient is pregnant and has thrombocytopenia and the labs as shown below, what is your diagnosis and why?

Throbotic thrombocytopenia purpura (TTP) because their ADAMTS13 is low.

How would you treat a patient with Thrombotic Thronbocytopenic purpura (TTP)?
They need an emergency plasma exchange to give them the ADAMTS13 that they are missing.
What can a factor V leiden test tell you about the present or absence of a clot?
NOTHING - I repeat - NOTHING!
It is NOT a helpful diagnostic took to determine if something has a clot or not.
What does elevated D-dimer indicate?
Suggests recent activity of thrombosis and fibrinolysis causing fibrin degradation.
When you first start warfarin you are ________, because of a decrease in ______.
Hypercoagulable due to a decrease in protein C.
This is why they need heparin bridge (ie to reduce coagulability) until their INR becomes therapeutic.
What (bad thing) can occur during a heparin bridge for a patient trying to reach therapeutic warfarin levels?
Heparin induced thrombocytopenia. IE a drug-induced antibody mediated platelet destruction with consumption.
(your body makes an auto-antibody to heparin)